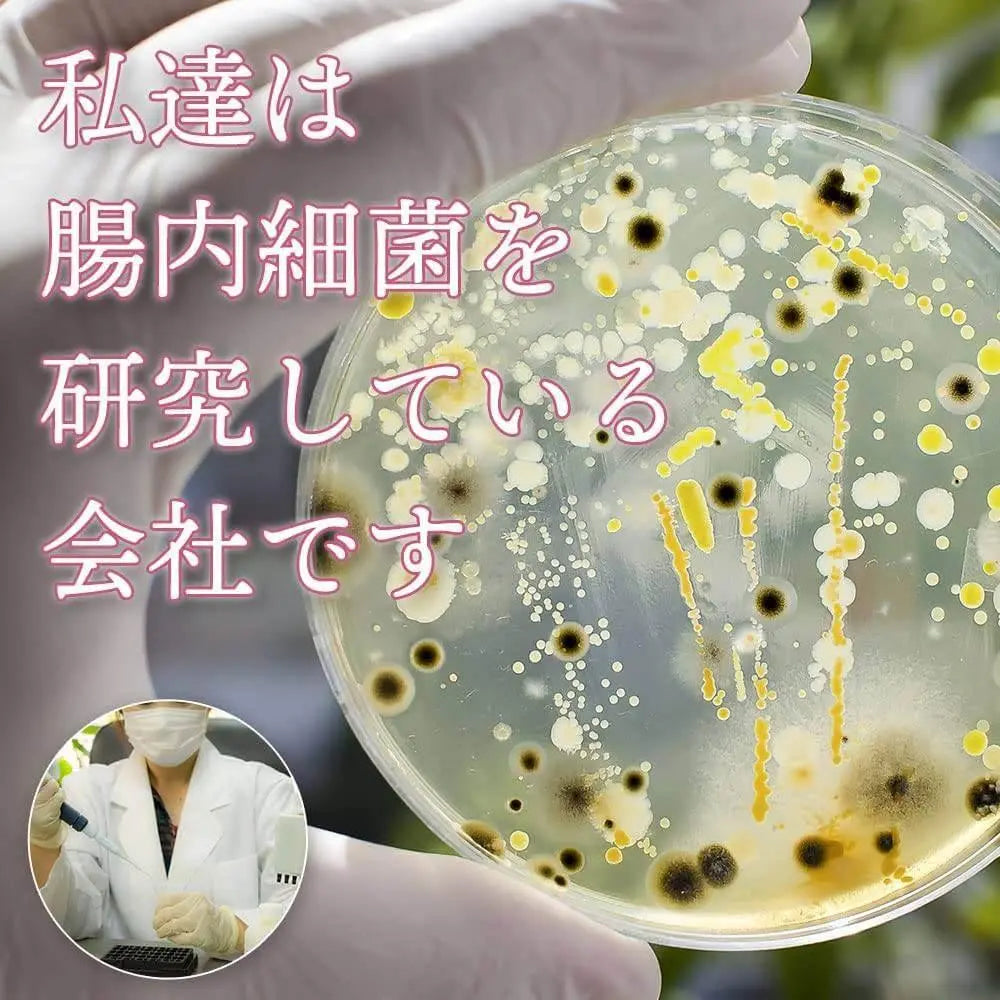
「Human100-NMN」含有9000mg NMN的國產補充劑

HEALTH
"Human100-NMN" A domestic supplement containing 9000mg of NMN
"Human100-NMN" A domestic supplement containing 9000mg of NMN
Couldn't load pickup availability
Contains 9,000 mg NMN per bag
Content: 60g Ingredients: water-soluble dietary fiber, NMN (purity above 98%), resveratrol
NMN bulk powder dosage: 9000mg/1 bag Application: Anti-aging care Estimated intake: 2 grams per day
What is NMN?
The official name of NMN is "nicotinamide mononucleotide", which is one of the base complexes produced in nature and in the body. It is also a form of vitamin B3. As we age, the production of NMN in our bodies decreases, accelerating cell death (i.e. aging).
"Supplement NMN and pursue health and longevity"
Human100-NMN is a supplement launched with this concept.
Living longer means rethinking your diet and living environment, as well as your health and, by extension, the ecosystem within you. We propose NMN as part of our value of listening to our inner voice.
Natural Polyphenol Resveratrol is a polyphenol found in red wine and other commonly talked about foods. It is a natural component produced by plants when they are stressed. The more stressed vegetables and fruits are in harsh natural environments, the tastier they become, but in the case of grapes, the more stressed they are, the more resveratrol they produce, which is said to benefit the survival of the plants themselves. There are many research publications investigating the relationship between resveratrol and lifespan, disease, and health.
About Us After joint research with universities, we have established our own laboratory to conduct research and analysis of intestinal bacteria/oral bacteria.
To date, we have analyzed intestinal bacteria in nearly 1,000 samples in our laboratory for healthcare research.
We developed this supplement based on the knowledge gained during the process.
We repeat front and back verification every day and strive to create better products.
9000 mg NMN per bag
Also contains resveratrol
1 bag for 1 month (2g used daily)
Most popular categories
-
health food
health food